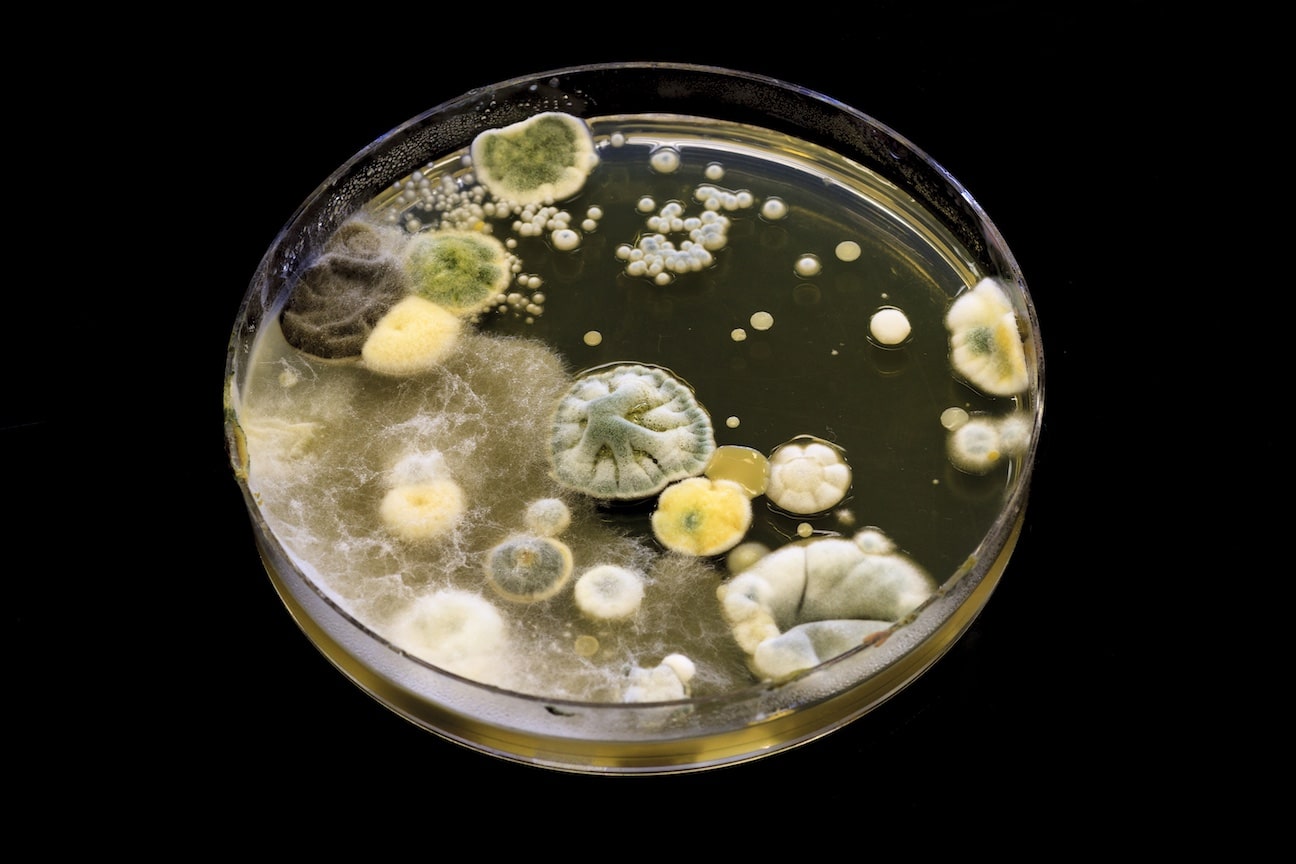
Mold growing on agar in a petri dish

The following article on Cannabis Testing & Safety was written by Mitch Anderson
Cannabis Legalization

The recreational cannabis industry has experienced remarkable growth since 2014, projecting a revenue of $43 billion in 2024. Just a decade ago, before Colorado legalized recreational cannabis, the annual revenue was merely $1.5 billion. The rapid expansion and widespread acceptance of the plant and its derivative products are undeniable. With potential rescheduling on the horizon and the implications of new oversight and regulation, it is crucial for both direct and adjacent operators to be prepared for what lies ahead.

The focal point of any broad cannabis legalization will be consumer safety, an area in which no state is currently fully prepared. While license holders will undoubtedly witness changes in their operational procedures to maintain compliance, the most significant transformations will likely occur within an adjacent industry – specifically, cannabis testing. At this time, cannabis testing laboratories nationwide face weak regulations and enforcement, leading to considerable variability in the safety of products.
Cannabis Testing Regulations

The primary issue lies in the failure of regulators to establish a robust system from the outset. As a result, many states have found themselves in situations where inadequate regulation and supervision allowed toxic products to enter the consumer market, resulting in adverse health outcomes, and in some cases, fatalities [1, 2, 3].
Molds
While some regulations are sensible, others appear to have been copied and pasted from unrelated legislation without proper consideration. For instance, the requirement for Aspergillus testing, a common mold found in numerous agricultural products, raises questions. Should we test for Aspergillus? Absolutely. However, does the absence of Aspergillus confirm with certainty that a product is safe? Absolutely not.
Several species of Aspergillus and other fungi produce mycotoxins, which are known to cause severe illnesses in humans, including cancer, liver damage, and immune suppression [4, 5, 6]. These compounds are extremely challenging to remove from products, are not effectively destroyed by heat [7, 8, 9, 10], and remain present regardless of the growth of mold [7]. Undoubtedly, this is a matter of significant concern.
Mycotoxins

In many states, cannabis products are permitted to undergo remediation, which involves cleaning the product through extraction and distillation if it fails testing for any reason. While this practice is generally considered safe, it is ineffective at eliminating mycotoxins. What is particularly frustrating is that many states that mandate mold testing do not require testing for mycotoxins. Consequently, a product contaminated at one point and subsequently remediated could test negative for mold but still be highly toxic for consumption. Mycotoxins are undoubtedly concerning, but heavy metals are even more alarming. Lead, arsenic, and cadmium are prevalent contaminants found across the country. Cannabis, being a “hyperaccumulator,” excels at extracting compounds from the soil and water used for its cultivation.
Heavy Metals

In addition to molds and mycotoxins, even small amounts of these heavy metals can become concentrated to toxic levels as the plant matures and approaches harvest time. As many cannabis consumers are parents, aunts, uncles, and grandparents, it is crucial to acknowledge that children are especially vulnerable to toxic lead exposure, with well-established severe physiological consequences in the medical community [11, 12].
Furthermore, if cannabis contaminated with lead is smoked in a home, it will settle wherever the smoke has touched, thereby potentially coating the floors, walls, and furniture with toxic substances. As a result, this poses a significant risk of causing severe intellectual & developmental deficits for which there is no treatment [13].
Conclusion

In conclusion, my argument is not that parents, aunts, uncles, and grandparents should cease cannabis consumption. Instead, it is that cannabis testing regulations fall short in safeguarding both consumers and those around them. As an industry, we have a responsibility to prioritize consumer safety. The legacy of cannabis legalization must not be marred by harm. Too many individuals have fought tirelessly for legal access to this vital plant, and failing to prioritize consumer safety would dishonor their efforts and memory.
Citations
[1] Hamadeh R, Ardehali A, Locksley RM, York MK. Fatal aspergillosis associated with smoking contaminated marijuana, in a marrow transplant recipient. Chest. 1988 Aug;94(2):432-3. doi: 10.1378/chest.94.2.432. PMID: 3293934.
[2] Gargani Y, Bishop P, Denning DW. Too many mouldy joints – marijuana and chronic pulmonary aspergillosis. Mediterr J Hematol Infect Dis. 2011;3(1):e2011005. doi: 10.4084/MJHID.2011.005. Epub 2011 Jan 14. PMID: 21625309; PMCID: PMC3103256.
[3] Department of Cannabis Control – State of California. (n.d.). Cannabis recalls and safety notices. Department of Cannabis Control. https://cannabis.ca.gov/resources/cannabis-recalls-and-safety-notices/
[4] Awuchi CG, Ondari EN, Nwozo S, Odongo GA, Eseoghene IJ, Twinomuhwezi H, Ogbonna CU, Upadhyay AK, Adeleye AO, Okpala COR. Mycotoxins’ Toxicological Mechanisms Involving Humans, Livestock and Their Associated Health Concerns: A Review. Toxins (Basel). 2022 Feb 24;14(3):167. doi: 10.3390/toxins14030167. PMID: 35324664; PMCID: PMC8949390.
[5] Fung, F., & Clark, R. F. (2004). Health Effects of Mycotoxins: A Toxicological Overview. Journal of Toxicology: Clinical Toxicology, 42(2), 217–234. https://doi.org/10.1081/CLT-120030947
[6] Peraica M, Radić B, Lucić A, Pavlović M. Toxic effects of mycotoxins in humans. Bull World Health Organ. 1999;77(9):754-66. PMID: 10534900; PMCID: PMC2557730.
[7] Goldblatt, L.A. Control and removal of aflatoxin. J Am Oil Chem Soc 48, 605–610 (1971). https://doi.org/10.1007/BF02544572
[8] Sipos P, Peles F, Brassó DL, Béri B, Pusztahelyi T, Pócsi I, Győri Z. Physical and Chemical Methods for Reduction in Aflatoxin Content of Feed and Food. Toxins (Basel). 2021 Mar 12;13(3):204. doi: 10.3390/toxins13030204. PMID: 33808964; PMCID: PMC7999035.
[9] Kabak, Bulent. (2009). jsfa.3491of mycotoxins during thermal food processing. Journal of the Science of Food and Agriculture. 89. 549 – 554. 10.1002/jsfa.349.
[10] Kabak, Bulent. (2009). jsfa.3491of mycotoxins during thermal food processing. Journal of the Science of Food and Agriculture. 89. 549 – 554. 10.1002/jsfa.3491.
[11] Al Osman M, Yang F, Massey IY. Exposure routes and health effects of heavy metals on children. Biometals. 2019 Aug;32(4):563-573. doi: 10.1007/s10534-019-00193-5. Epub 2019 Apr 2. PMID: 30941546.
[12] Zheng K, Zeng Z, Tian Q, Huang J, Zhong Q, Huo X. Epidemiological evidence for the effect of environmental heavy metal exposure on the immune system in children. Sci Total Environ. 2023 Apr 10;868:161691. doi: 10.1016/j.scitotenv.2023.161691. Epub 2023 Jan 18. PMID: 36669659.
[13] Abelsohn AR, Sanborn M. Lead and children: clinical management for family physicians. Can Fam Physician. 2010 Jun;56(6):531-5. PMID: 20547517; PMCID: PMC2902938.
Please consume responsibly. For use only by adults 21 and older; Keep out of reach of children; Additionally, this product is not approved by the FDA to treat, cure, or prevent any disease. Further, the FDA has not evaluated this product for safety, effectiveness, and quality; Do not drive a motor vehicle or operate machinery while under the influence of cannabis; In addition, there may be long-term adverse health effects from consumption of cannabis, including additional risks for women who are or may become pregnant or are breastfeeding.




